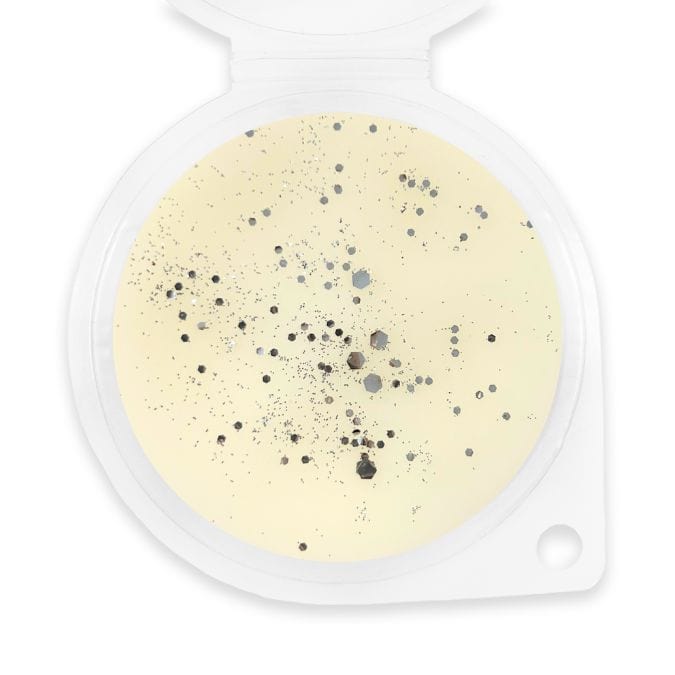

White Linen Wax Melt
- In stock, ready to ship
- Inventory on the way
30 DAY SATISFACTION GUARANTEE
Since 2019, Sassy Scents is the UK's favourite wax melts. Over a million of our products have blessed people with comforting homes that smells great. Order confidently with our 30-day, no hassle Satisfaction Guarantee.
Elevate your senses with White Linen Wax Melt. Lovingly made in the UK, this vegan and eco-conscious wax melt infuses your space with its captivating scent. Sassy Scents: Unrivaled leaders in quality Wax Melts. Handcrafted for perfection, our eco-friendly, UK-made melts offer unparalleled aromas
We aim to dispatch orders the next working day using the Royal Mail 48hour service. Please allow 3-5 days for delivery.
Please contact customercare@sassyshopwax.com if you have any questions
How to use: Each wax melt contains 5 pieces of heart-shaped wax. Break off one or two heart pieces from your wax melt, add a tea light underneath, and light the tealight wick. Keep using new tealights until you can no longer smell the scent. If using Sassy Wax Original Warmer - Electric Wax Burner: Break off a segment/heart from your wax melt, and add to the bowl at the top of the burner. Press the button on the burner once for a 3-hour burn, twice for a 6-hour burn and 3 times for a 9-hour burn. Your wax melt burner will turn off after the selected time. If you want to turn it off early, click the button until all lights are off. If you burn 13g this will be somewhere around approx 12-18 hours of scent in total.
The intensity of the fragrance will depend on your room size, the temperature of the room and the amount of wax used. For best results, always close your windows in the room you are burning the wax. Once the wax is spent, use cotton balls/pads to soak up melted/molten wax and then dispose of it accordingly. Do not use wipes and/or cleaning chemicals/products to clean the burner. Do not use metal or sharp objects to clean out wax as this may crack or damage the burner or cause injury. Please check the packaging for allergen advice. Keep away from children.
What is a wax melt?
Wax melts are scented pieces of wax, much like a candle but without the wick. We have an unbeatable range of scents and fragrances ranging from perfume to laundry. Click here to read our blog post about wax melts.
Are wax melts better than candles?
We say YES! Wax melts are much better than candles for a number of reasons. For a £20 high street candle, you get 1 scent and the candle is likely to produce black soot and other unwanted nasties. For the same money you can get over 6 different scents with a total melt time of up to 540 hours!
How long do wax melts last?
Two cubes of sassy wax melts can last up to 18 hours of scent! Wax melts are better than candles in terms of value for money.
How often should I change the wax in my wax warmer?
We recommend switching to a fresh wax melt ever 2-3 4 hour tea lights.
What wax melter should I use?
We recommend using a tea light burner for optimal scent throw but our wax melts can also be used in electric wax burners and plug in warmers.
What is scent throw?
Scent throw is a term used to describe how strong the fragrance is and how quickly the scent travels. A good was melt will fill the room with strong fragrance within 10 minutes of melting.
Do wax melts evaporate?
Unlike candles, wax melts do not come into contact with a naked flame so do not evaporate. Simply burn the same piece of wax until you no longer can smell the scent and dispose of the residual wax.
How do you remove wax melts?
We have 2 favourite ways of removing wax melts from a wax burner. Firstly, we love to use cotton wool or cotton pads to soak up the molten wax and wipe the dish clean. Secondly, you can wait for the wax to set hard and run the dish under a warm tap so the wax pops out with ease. Make sure you completely dry your wax burner dish before using again.
How do you clean a wax warmer dish?
With both of our methods above you will be able to remove your wax with a clean dish every time.
Do you use biodegradable glitter in your wax melts?
Yes we do!
Can I reuse wax melts?
Once the scent throw has gone, we recommend switching your wax melt for a fresh one. After all, two cubes cost just 60p and last up to 18 hours making our wax melts much better than candle alternatives.
Where can I find your wax melt reviews?
We have over 400 5* reviews on our Facebook Page. you can also find 5* reviews Trust Pilot and Google. We also have a review highlight on our instagram
How long are delivery times?
We aim to dispatch all orders on following working day.
We use the Royal Mail Tracked48 service. Delivery is between 2-5 days after date of order.
What is your 30 day guarantee policy?
We also offer a 30-day money-back guarantee, this means that any products you are not satisfied with can be returned to us within 30 days of purchase in their original condition and packaging for a full refund. Just let our customer care team know to expect them prior to making the return and post to:
Sassy Shop Wax, Unit 11 Vertex Park, Oakwood Drive, Emerson's Green, Bristol, BS16 7LB
Return postage is covered by the customer. If you are returning an item(s), you should consider using a trackable shipping service. We don’t guarantee that we will receive your returned item.
After we receive your item, our team of professionals will inspect it and process your refund. The money will be refunded to the original payment method you’ve used during the purchase. For credit card payments it may take 5 to 10 business days for a refund to show up on your credit card statement.
If you have any additional questions or would like to request a refund, feel free to contact us at customercare@sassyshopwax.com.